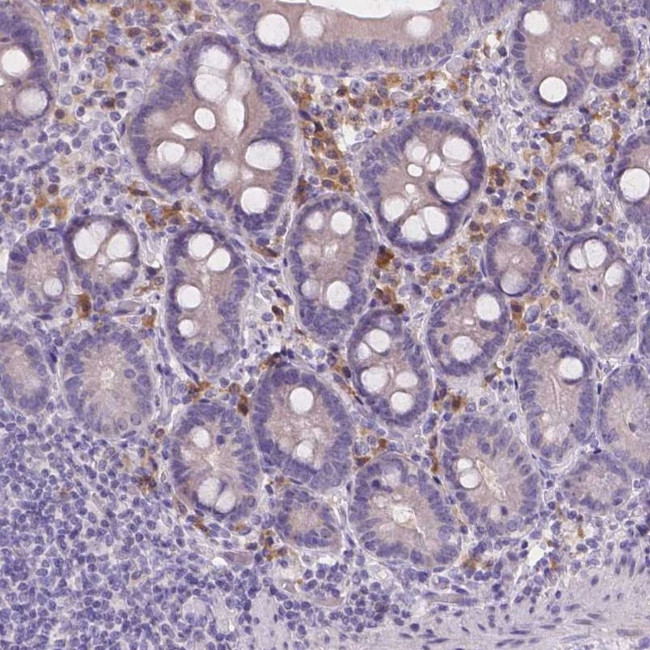
CD96 Antibody in Immunohistochemistry (IHC)

Search
Invitrogen
CD96 Polyclonal Antibody
{{$productOrderCtrl.translations['antibody.pdp.commerceCard.promotion.promotions']}}
{{$productOrderCtrl.translations['antibody.pdp.commerceCard.promotion.viewpromo']}}
{{$productOrderCtrl.translations['antibody.pdp.commerceCard.promotion.promocode']}}: {{promo.promoCode}} {{promo.promoTitle}} {{promo.promoDescription}}. {{$productOrderCtrl.translations['antibody.pdp.commerceCard.promotion.learnmore']}}
产品信息
PA5-147391
种属反应
宿主/亚型
分类
类型
抗原
偶联物
形式
浓度
规格
纯化类型
保存液
内含物
保存条件
运输条件
RRID
产品详细信息
Immunogen sequence: VPGNKVWNIS SEKITFLLGS EISSTDPPLS VTESTLDTQP SPASSVSPAR YPATSSVTLV DVSALRPNTT PQPSNSSMTT
Highest antigen sequence identity to the following orthologs: Mouse - 54%, Rat - 56%.
靶标信息
CD96 is a cell adhesion receptor also known as TACTILE. A member of the Ig superfamily, CD96 is a single pass transmembrane protein consisting of three extracellular Ig-like domains and a proline/serine/threonine rich region. CD96 is expressed on resident monocytes and T cells at all developmental stages (including gamma-delta T cells, thymocytes, and NK cells). In the mouse, this receptor is not expressed on B cells. Unlike in humans, mouse CD96 does not exist as alternative splice variants. Reports indicate that CD96 binds CD155/poliovirus receptor and Nectin-1 to mediate NK cell adhesion to target cells and cytotoxicity.
仅用于科研。不用于诊断过程。未经明确授权不得转售。
篇参考文献 (0)
生物信息学
蛋白别名: CD96; Cell surface antigen CD96; DKFZp667E2122; sCD96; soluble CD96; T cell activation, increased late expression; T cell-activated increased late expression protein; T-cell surface protein tactile; unnamed protein product
基因别名: CD96; TACTILE
UniProt ID: (Human) P40200
Entrez Gene ID: (Human) 10225